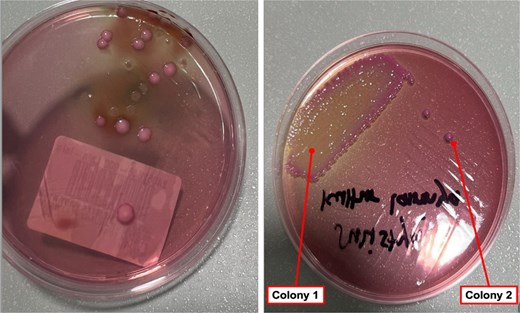
Different phenotypes of Klebsiella pneumoniae on MacConkey agar were isolated from various specimens in the same patients. The colonies from the tissue specimen (a), along with the mucoid (colony 1) and non-mucoid (colony 2) colonies from the implant specimen (b), may indicate biofilm formation on the implant surface.

-
PDF
- Split View
-
Views
-
Cite
Cite
Achmad Zaki, Erike A Suwarsono, Azmul A Irfan, Harningtyas A Jasmin, Orthopedic implant-related ESBL Klebsiella pneumoniae infection post-ORIF surgery: a case report, Journal of Surgical Case Reports, Volume 2025, Issue 10, October 2025, rjaf860, https://doi.org/10.1093/jscr/rjaf860
Close - Share Icon Share
Abstract
Implant-related bacterial infection remains a major issue. Particularly caused by Klebsiella pneumoniae. A 35-year-old female, 3 months post open reduction and internal fixation for right cruris fracture, presented with infection symptoms. She underwent implant removal and surgical debridement. Microbiological samples from pus, infected tissue, and implant confirmed K. pneumoniae infection with Extended Spectrum Beta-Lactamase production. Post-surgery, she received meropenem for 5 days, followed by oral one-gram fosfomycin for 2 days. No signs of infection were detected within a week. Regardless of healing process is achieved; removing the implant will improve the outcome. The surface of implants is prone to bacterial colonization, which can lead to the development of antibiotic resistance. This paper presents a case of implant-related bacterial infection. Implant-related K. pneumoniae infection could lead to antimicrobial-resistant organisms that increase the probability of difficult-to-treat conditions. Removing the implant, combined with antibiotic delivery, could be the best approach.
Introduction
Orthopedic implant-related infections are a significant concern [1], often leading to prolonged treatment, economic burden, and decreased quality of life. Their prevalence is up to 5% of all orthopedic procedures [1]. Fracture-related infection occurs in connection with bone fractures, usually involving implant fixation, and in this case, was linked to procedures at a different medical facility [2].
Klebsiella pneumoniae and Staphylococcus aureus are most responsible for implant-related cases of infection [3–4]. K. pneumoniae is known as an encapsulated bacterium with virulence factors that facilitate biofilm formation [5]. The emergence of hypervirulent strains with multidrug-resistant phenotypes, such as Extended-Spectrum Beta-Lactamase (ESBL) and K. pneumoniae Carbapenems-producing strain, has complicated treatment [6]. ESBL-producing strains are resistant to first- to third-generation of cephalosporine, aztreonam, and sometimes ciprofloxacin, while K. pneumoniae Carbapenems strains are resistant to all beta-lactam antibiotics. Several studies have shown that biofilm formation leads to antimicrobial resistance. Biofilm formation, driven by K. pneumoniae capsular structure, type 3 fimbriae, and other virulence factors, leads to the development of bacterial communities [7, 8].
Biofilm-related infections on orthopedic implants are difficult to eradicate. Therefore, comprehensive management is essential. This case report provides evidence that both antibiotic administration and infection source control surgery are required to manage implant-related infection due to antimicrobial-resistant pathogen strains.
Case report
A 35-year-old female patient, who underwent open reduction and internal fixation on her lower left leg 3 months ago at another hospital, presented to our facility with a fever and an infected post-surgical wound, with pus, redness, swelling, crust, and pain (Fig. 1). A month prior, she had visited the dermatology outpatient clinic with similar symptoms and was diagnosed with hypersensitivity to orthopedic implants, for which she received corticosteroid. No history of past illness or routine medication was known. Her nutritional status was within normal ranges, with body mass index of 27.6 kg/m2. Routine laboratory tests were unremarkable. As bone union was achieved, the implant was removed and surgical debridement performed 2 days after admission.

Clinical presentation of patient upon admission before implant removal surgery (a); The X-ray result taken on the same day, shows the implant in place (b).
Microbiological samples from pus, infected tissue, and implants were collected. Pus and tissue samples were taken from areas near the bone and implant (Fig. 2) and incubated in thioglycolate, blood sheep, MacConkey, and chocolate agar in 3%–5% CO2 for 18–24 hours. After implant removal, the implant surface was swabbed under sterile conditions, and the swab was directly streaked onto blood sheep and MacConkey agar, and then incubated under the same condition. Bacterial identification and antimicrobial susceptibility testing were assessed using the VITEX2 automated system.

Infected tissue surrounding the implant as observed during surgery (a and b).
Both tissue and pus samples tested positive for ESBL-producing K. pneumoniae. Two distinct colonies on agar indicated biofilm formation (Fig. 3). Table 1 summarizes the microbiological and susceptibility results for colonies from the implant and tissue. During hospitalization, the patient received 1 g of meropenem every 8 hours and was discharged 5 days post-surgery with 2 days of oral Fosfomycin. At follow-up in the outpatient clinic 1 week later, no signs of infection were observed (Fig. 4).
Different phenotypes of Klebsiella pneumoniae on MacConkey agar were isolated from various specimens in the same patients. The colonies from the tissue specimen (a), along with the mucoid (colony 1) and non-mucoid (colony 2) colonies from the implant specimen (b), may indicate biofilm formation on the implant surface.
| All isolates detected: Klebsiella pneumoniae ssp pneumoniae . | Specimen . | ||
|---|---|---|---|
| Body tissue . | Implant 1st Isolate . | Implant 2nd Isolate . | |
| Antibiotics | MIC (ug/ml)/(susceptibility) | ||
| ESBL | Positive | Positive | Positive |
| Cefazolin | >32 (R) | >32 (R) | >32 (R) |
| Ceftriaxone | >32 (R) | >32 (R) | >32 (R) |
| Gentamicin | >8 (R) | >8 (R) | >8 (R) |
| Amikacin | 4 (S) | 4 (S) | 4 (S) |
| Ampicillin–Sulbactam | >16 (R) | >16 (R) | >16 (R) |
| Piperacillin–Tazobactam | 32 (I)* | 16 (S)* | 16 (S)* |
| Ceftazidime | 16 (R) | 16 (R) | 16 (R) |
| Cefepime | 4 (R) | 4 (R)** | 2 (R)** |
| Cotrimoxazole | >160 (R) | >160 (R) | >160 (R) |
| Tigecycline | 2 (S) | 2 (S) | 2 (S) |
| Aztreonam | 16 (R) | 16 (R) | 16 (R) |
| Meropenem | ≤ 0.25 (S) | ≤ 0.25 (S) | ≤ 0.25 (S) |
| Ertapenem | ≤0.5 (S) | ≤ 0.5 (S) | ≤ 0.5 (S) |
| Ciprofloxacin | >2 (R) | >2 (R) | >2 (R) |
| All isolates detected: Klebsiella pneumoniae ssp pneumoniae . | Specimen . | ||
|---|---|---|---|
| Body tissue . | Implant 1st Isolate . | Implant 2nd Isolate . | |
| Antibiotics | MIC (ug/ml)/(susceptibility) | ||
| ESBL | Positive | Positive | Positive |
| Cefazolin | >32 (R) | >32 (R) | >32 (R) |
| Ceftriaxone | >32 (R) | >32 (R) | >32 (R) |
| Gentamicin | >8 (R) | >8 (R) | >8 (R) |
| Amikacin | 4 (S) | 4 (S) | 4 (S) |
| Ampicillin–Sulbactam | >16 (R) | >16 (R) | >16 (R) |
| Piperacillin–Tazobactam | 32 (I)* | 16 (S)* | 16 (S)* |
| Ceftazidime | 16 (R) | 16 (R) | 16 (R) |
| Cefepime | 4 (R) | 4 (R)** | 2 (R)** |
| Cotrimoxazole | >160 (R) | >160 (R) | >160 (R) |
| Tigecycline | 2 (S) | 2 (S) | 2 (S) |
| Aztreonam | 16 (R) | 16 (R) | 16 (R) |
| Meropenem | ≤ 0.25 (S) | ≤ 0.25 (S) | ≤ 0.25 (S) |
| Ertapenem | ≤0.5 (S) | ≤ 0.5 (S) | ≤ 0.5 (S) |
| Ciprofloxacin | >2 (R) | >2 (R) | >2 (R) |
R = resistant; I = Intermediate; S = Susceptible.
*, ** = different susceptibility pattern in each isolate that can tend to different genomic traits of K. pneumoniae.
| All isolates detected: Klebsiella pneumoniae ssp pneumoniae . | Specimen . | ||
|---|---|---|---|
| Body tissue . | Implant 1st Isolate . | Implant 2nd Isolate . | |
| Antibiotics | MIC (ug/ml)/(susceptibility) | ||
| ESBL | Positive | Positive | Positive |
| Cefazolin | >32 (R) | >32 (R) | >32 (R) |
| Ceftriaxone | >32 (R) | >32 (R) | >32 (R) |
| Gentamicin | >8 (R) | >8 (R) | >8 (R) |
| Amikacin | 4 (S) | 4 (S) | 4 (S) |
| Ampicillin–Sulbactam | >16 (R) | >16 (R) | >16 (R) |
| Piperacillin–Tazobactam | 32 (I)* | 16 (S)* | 16 (S)* |
| Ceftazidime | 16 (R) | 16 (R) | 16 (R) |
| Cefepime | 4 (R) | 4 (R)** | 2 (R)** |
| Cotrimoxazole | >160 (R) | >160 (R) | >160 (R) |
| Tigecycline | 2 (S) | 2 (S) | 2 (S) |
| Aztreonam | 16 (R) | 16 (R) | 16 (R) |
| Meropenem | ≤ 0.25 (S) | ≤ 0.25 (S) | ≤ 0.25 (S) |
| Ertapenem | ≤0.5 (S) | ≤ 0.5 (S) | ≤ 0.5 (S) |
| Ciprofloxacin | >2 (R) | >2 (R) | >2 (R) |
| All isolates detected: Klebsiella pneumoniae ssp pneumoniae . | Specimen . | ||
|---|---|---|---|
| Body tissue . | Implant 1st Isolate . | Implant 2nd Isolate . | |
| Antibiotics | MIC (ug/ml)/(susceptibility) | ||
| ESBL | Positive | Positive | Positive |
| Cefazolin | >32 (R) | >32 (R) | >32 (R) |
| Ceftriaxone | >32 (R) | >32 (R) | >32 (R) |
| Gentamicin | >8 (R) | >8 (R) | >8 (R) |
| Amikacin | 4 (S) | 4 (S) | 4 (S) |
| Ampicillin–Sulbactam | >16 (R) | >16 (R) | >16 (R) |
| Piperacillin–Tazobactam | 32 (I)* | 16 (S)* | 16 (S)* |
| Ceftazidime | 16 (R) | 16 (R) | 16 (R) |
| Cefepime | 4 (R) | 4 (R)** | 2 (R)** |
| Cotrimoxazole | >160 (R) | >160 (R) | >160 (R) |
| Tigecycline | 2 (S) | 2 (S) | 2 (S) |
| Aztreonam | 16 (R) | 16 (R) | 16 (R) |
| Meropenem | ≤ 0.25 (S) | ≤ 0.25 (S) | ≤ 0.25 (S) |
| Ertapenem | ≤0.5 (S) | ≤ 0.5 (S) | ≤ 0.5 (S) |
| Ciprofloxacin | >2 (R) | >2 (R) | >2 (R) |
R = resistant; I = Intermediate; S = Susceptible.
*, ** = different susceptibility pattern in each isolate that can tend to different genomic traits of K. pneumoniae.

Clinical appearance of the surgical site 2 days after implant removal surgery (a); and 1 week post-surgery (b), showing progression in wound healing and resolution of infection signs.
Discussion
Orthopedic implants can harbor bacteria, leading to antibiotic resistance [3]. Rough, uneven surfaces promote bacterial attachment [3]. Bacteria prefer materials like titanium, polyethylene, and stainless steel for colonization [9]. After implantation, host cells and microbes compete to attach, a ‘race for surface’ [1]. An extracellular matrix (ECM) film is formed, with substances like polysaccharides and proteins, aiding bacterial adhesion. K. pneumoniae exploits this to survive and resist treatment [10].
Almost all K. pneumoniae produce biofilm (90.2%) [11], and hypervirulent, multi-resistant strains are emerging [5]. Key virulence factors are the capsule and type 3 fimbriae, which mediate biofilm formation and fimbrial binding [6]. A study found 98.8% of strains carried the mrkD protein, enabling adherence to collagen and ECM-coated surfaces, contributing to implant-related infection resistance [6, 11].
Figure 3 shows two colony types on MacConkey Agar: mucoid and non-mucoid. Table 1 highlights different antimicrobial resistance patterns, suggesting biofilm formation. Both colonies produce ESBL with different resistance profiles. The biofilm environment favors gene exchange, which could promote ESBL spread through bacterial conjugation, facilitating the transfer of resistance plasmids [12].
Another study observed that the biofilm forming Gram-negative organisms demonstrated a high resistance to piperacillin–tazobactam (80%), cefoperazone–sulbactum (75%), and meropenem (71%). Whereas non-biofilm-producing organisms showed high resistance to ciprofloxacin (95%), cotrimoxazole (60%), and ceftriaxone (75%) [13]. It is increasingly evident that bacteria on medical devices or in host niches coexist and synergize in polymicrobial biofilm communities [7].
Effective management of implant-related infections should not rely solely on antibiotics. Studies have shown that ~50% of implant-related infections caused by antibiotic-resistant Gram-negative bacteria are successfully treated through a combination of antimicrobials and surgery [14]. After a seven-day course of antibiotics, the patient showed improvement and no signs of infection. Recent studies have demonstrated that 7-day treatments are as effective as longer courses for various infections. The Infectious Diseases Society of America now recommends 5–7 day regimens for stable Gram-negative infections [15–17].
Debridement without implant removal has been associated with a high failure rate. Some studies show a strong relationship between implant removal and infection control. Thus, regardless of whether the fracture healing process is achieved, controlling the source of infection by removing or replacing the implant typically leads to better outcomes, even in ESBL infection [14].
Conclusion
Implant-related biofilm could lead to the development of antimicrobial resistant organisms that increase the complexity of treatment. Source control of infection by removing or replacing the implant with antibiotic delivery could be best option for implant-related ESBL infection management.
Acknowledgements
The authors acknowledge our orthopedic surgery team in the hospital.
Conflict of interest statement
The authors declare that they have no competing interest.
Funding
Not applicable.
Ethical approval
This study is exempt from institutional review board approval. The authors declare and certify that the patient has already given consent for publication. She had given her consent to use the images and all other clinical information for scientific purposes.
Data availability
The datasets used and/or analyzed during current study are available from corresponding author on reasonable request.